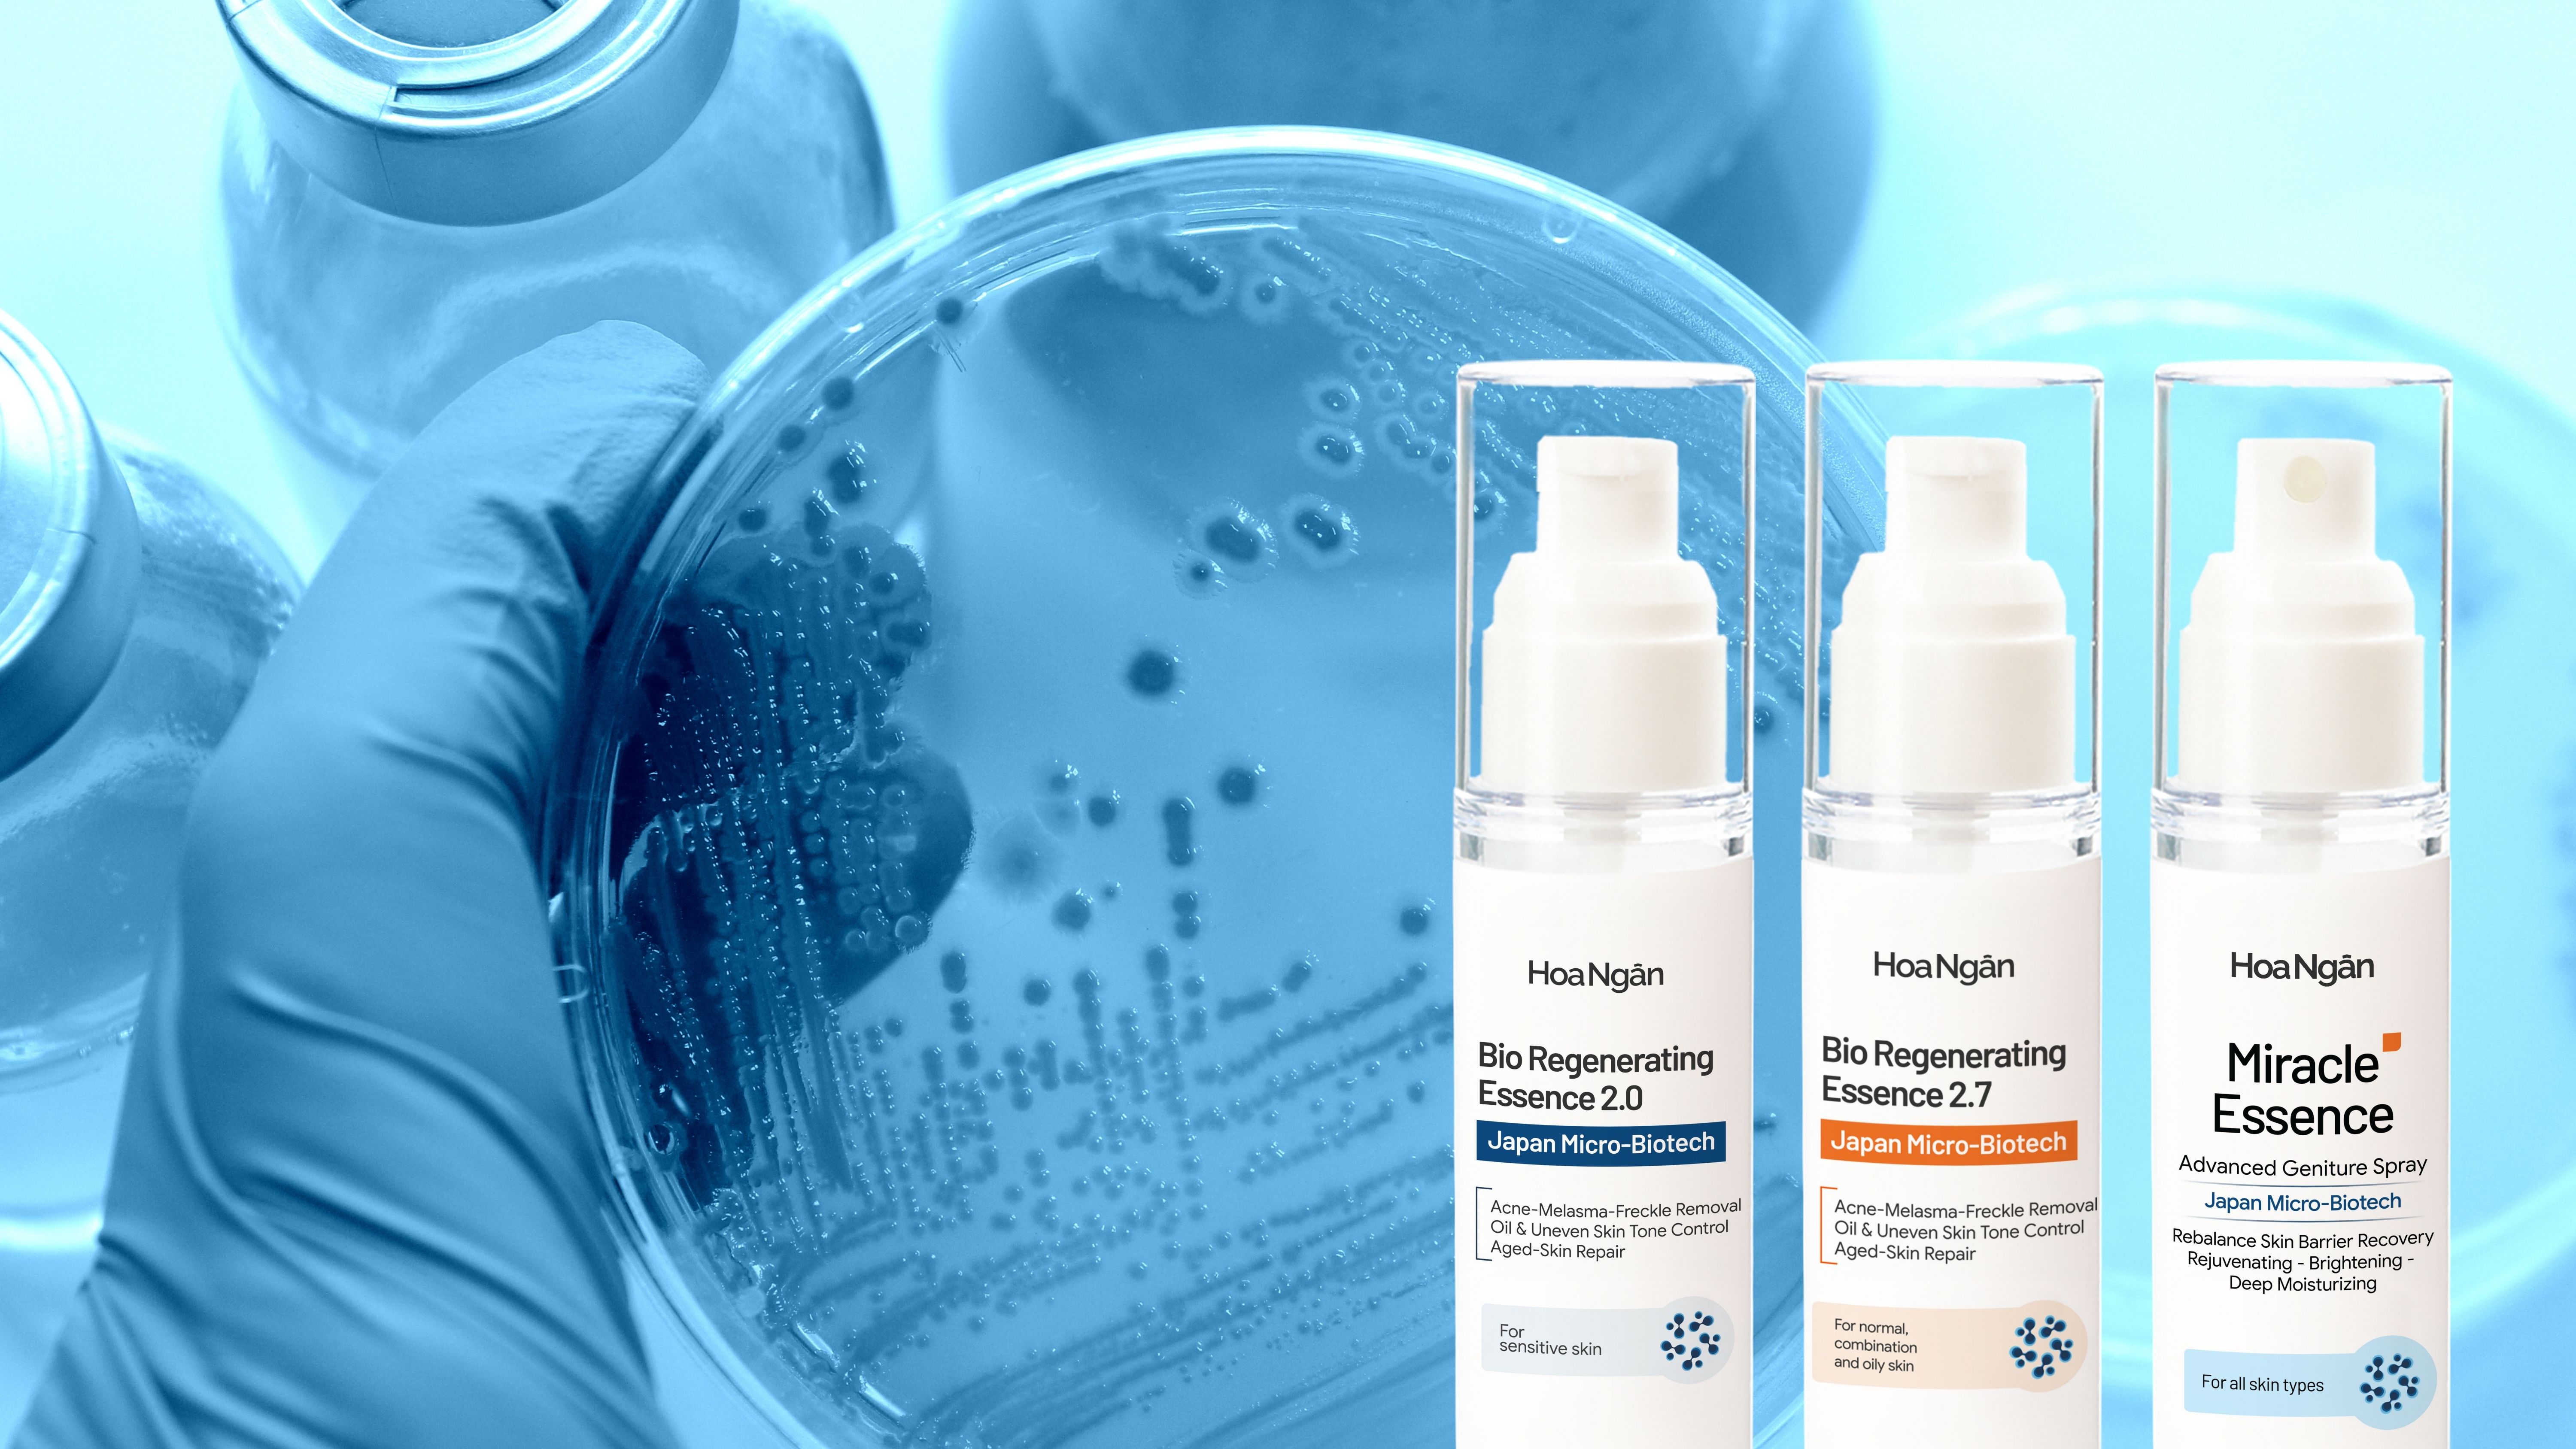
Mỹ phẩm vi sinh Hoa Ngân có phải kem trộn không? Sự thật bạn cần biết

Theo bạn 1 sản phẩm đạt tiêu chuẩn gì thì được gọi là "sản phẩm mỹ phẩm chứa probiotics"? Tạm gác lại những lời quảng cáo hấp... Đọc tiếp

Probiotic là lợi khuẩn, nhưng hệ vi sinh trên bề mặt da (microbiome) còn có những vi khuẩn gây hại và vi khuẩn trung tính. Bổ... Đọc tiếp

Bạn từng soi gương mỗi sáng và thấy làn da mình ngày càng yếu, mụn – nám – thâm cứ tái phát dù đã thử đủ... Đọc tiếp

Bên cạnh những thành tích nổi bật trong công việc, VCB chi nhánh Hóc Môn luôn đặt con người làm trọng tâm – quan tâm, chăm... Đọc tiếp

“Mua mỹ phẩm Vi sinh Hoa Ngân chính hãng ở đâu? Thực tế, ngày càng nhiều người gặp phải tình trạng mua nhầm hàng giả, hàng trôi... Đọc tiếp

Emhealthy là đại lý phân phối chính hãng mỹ phẩm vi sinh Hoa Ngân, mang đến các sản phẩm an toàn, lành tính, giúp làn da... Đọc tiếp
Trong thị trường làm đẹp hiện nay, không ít khách hàng hoang mang trước tình trạng kem trộn trá hình dưới nhiều nhãn mác mỹ phẩm.... Đọc tiếp

Khi còn là 1 em bé da chúng ta rất khỏe và đẹp nhưng khi lớn lên làn da làn da lại gặp nhiều vấn đề... Đọc tiếp

Trong thế giới làm đẹp ngày nay, mỹ phẩm lợi khuẩn đang trở thành một xu hướng phổ biến. Tuy nhiên, việc chọn lựa sản phẩm... Đọc tiếp